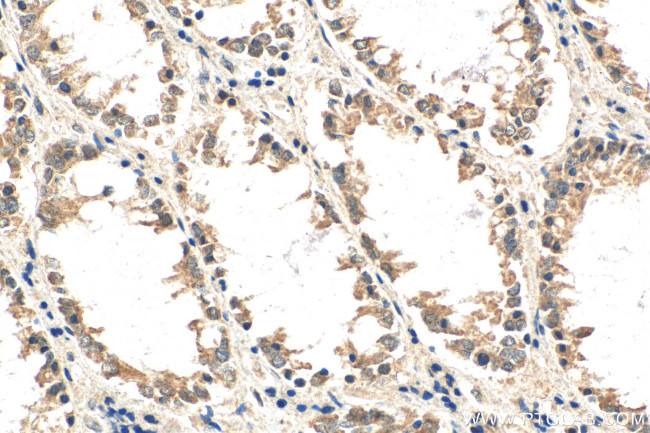
WISP3 Antibody in Immunohistochemistry (Paraffin) (IHC (P))

Search
Proteintech
WISP3 Polyclonal Antibody
{{$productOrderCtrl.translations['antibody.pdp.commerceCard.promotion.promotions']}}
{{$productOrderCtrl.translations['antibody.pdp.commerceCard.promotion.viewpromo']}}
{{$productOrderCtrl.translations['antibody.pdp.commerceCard.promotion.promocode']}}: {{promo.promoCode}} {{promo.promoTitle}} {{promo.promoDescription}}. {{$productOrderCtrl.translations['antibody.pdp.commerceCard.promotion.learnmore']}}
产品信息
21259-1-AP
种属反应
宿主/亚型
分类
类型
抗原
偶联物
形式
浓度
规格
纯化类型
保存液
内含物
保存条件
运输条件
产品详细信息
Aliquoting is unnecessary for -20°C storage.
靶标信息
WISP3 is a member of the WNT1 inducible signaling pathway (WISP) protein subfamily, which belongs to the connective tissue growth factor (CTGF) family. WNT1 is a member of a family of cysteine-rich, glycosylated signaling proteins that mediate diverse developmental processes. The CTGF family members are characterized by four conserved cysteine-rich domains: insulin-like growth factor-binding domain, von Willebrand factor type C module, thrombospondin domain and C-terminal cystine knot-like domain. WISP3 is overexpressed in colon tumors. It may be downstream in the WNT1 signaling pathway that is relevant to malignant transformation. Mutations of the WISP3 gene are associated with progressive pseudorheumatoid dysplasia, an autosomal recessive skeletal disorder, indicating that the gene is essential for normal postnatal skeletal growth and cartilage homeostasis.
仅用于科研。不用于诊断过程。未经明确授权不得转售。
篇参考文献 (0)
生物信息学
蛋白别名: CCN family member 6; Cellular communication network factor 6; epididymis secretory sperm binding protein; putative IGF-binding protein; WISP-3; WNT1 inducible signaling pathway protein 3; WNT1-inducible-signaling pathway protein 3
基因别名: CCN6; LIBC; PPAC; PPD; PPRD; UNQ462/PRO790/PRO956; WISP-3; WISP3
UniProt ID: (Human) O95389
Entrez Gene ID: (Human) 8838